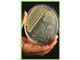
فروش انواع محیط کشت میکروبی - سلولی - محیط کشت آگارآگار- محیط کشت emb
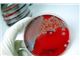
فروش انواع محیط کشت میکروبی - سلولی - محیط کشت آگارآگار- محیط کشت emb
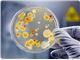
فروش انواع محیط کشت میکروبی - سلولی - محیط کشت آگارآگار- محیط کشت emb

فروش انواع محیط کشت میکروبی - سلولی - محیط کشت آگارآگار- محیط کشت emb
اگار اگار- بلاد اگار- BLOOD AGAR- براٍث - اسیلوس سرئوس اگار- BACILLUS SEREUS AGAR - برلیانت گرین اگار- BGA-دکستروز اگار- دزوکسی سیترات اگار- مکانکی اگار- ام ار اس برات - نوترینت اگار- اورنج سرم اگار- پلانت کانت اگار- SS AGAR - تریبسین پودر- اس اس اگار- سلنیت سیستیین برات – TSA - تی اس بی اگار – محیط کشت برلیانت گرین بایل براث – محیط کشت تریپتون واتر
قیمت
- قیت همکار / عمده فروشی :
اطلاعات تامین کننده
سدید تجهیز طوبی(تجهیزات آزمایشگاهی ،شیشه آلات و مواد اولیه صنایع غذایی)
تهرانعمده فروش، خرده فروش، خدمات
اتوکلاو - انکوباتورساده و یخچالدار، شیکر - میکسر- آون، سانتریفیوژ - میکروسکوپ - بن ماری جوش، انواع کیت های آزمایشگاهی، محیط کشت میکروبیولوژی - بیولوژی، وارد کننده تجهیرات آزمایشگاهی و پزشکی، تعمیرو کالیبراسیون تجهیزات آزمایشگاهی و پزشکی، ملزومات و شیشه آلات آزمایشگاهی، فروش موادشیمیایی آزمایشگاهی و صنعتی، مواد اولیه صنایع غذایی، رفرکتومتر- ترمومتر-ویسکوزیمتر، هود شیمیایی و میکروبی، کدورت سنج - دسیکاتور، ترازوهای دقیق آزمایشگاهی، ست شیشه ای فیلتراسیون، ترمومیکسر-پرسیدین 15%
مشاهده سایت فروشندهخرید از تامین کنندگان برتر پارس سنتر!

تامین کنندگان برتر پارس سنتر سرعت پاسخگویی بالاتر و محصولات بروز تری نسبت به سایر تامین کنندگان دارند.
مشخصات
- فروش انواع محیط کشت
- میکروبی - سلولی
توضیحات محصول
فروش انواع محیط کشت سلولی و میکروبی ازکمپانی های معتبر خارجی و ایرانی
محیط کشت (به انگلیسی: Growth medium) محیط دارای مایع یا ژل میباشد که به منظور رشد دادن میکروبها، یاختهها یا حتی گیاهان کوچک مورد استفاده قرار میگیرد. محیطهای کشت به طور معمول شامل دو دسته میباشند، کشت یاخته (به انگلیسی: cell culture) که در آن از یاختههای ویژهای استفاده مینمایند که از گیاهان و حیوانها به دست آمدهاند و کشت خردزیستی (به انگلیسی: microbiological culture) که به ویژه به منظور رشد دادن میکروبها استفاده میگردد، از رایج ترین انواع کشت خردزیستی میتوان به ظرف آگار و محیط کشت مایع مغذی اشاره نمود.
تلفکس: 88097680- 021
آدرس ایمیل :sadid.ttco@yahoo.com